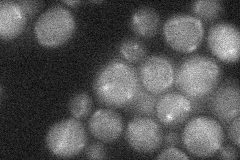
YJL126W
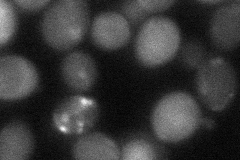
YJL126W
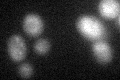
YJL126W

View description
Nit protein, one of two proteins in S. cerevisiae with similarity to the Nit domain of NitFhit from fly and worm and to the mouse and human Nit protein which interacts with the Fhit tumor suppressor; nitrilase superfamily member
Localization:
Intensity:
Fold change:
Significance:
-
C’ GFP library in SD

below threshold13.77 -
N' NOP1pr-GFP in SD

cytosol94.1199 -
N' TEF2pr-mCherry in SD

cytosol145.037 -
N' NATIVEpr-GFP in SD
below threshold23.4987 -
N' TEF2pr-VC and Cyto-VN in SD
cytosol37.4473 -
C’ GFP library in SD+DTT
cytosol14.551.05No -
C’ GFP library in SD+H2O2

cytosol16.961.23No -
C’ GFP library in Starvation Media

cytosol16.471.19No -
C’ GFP library on the background of Pup2-DaMP

N/A -
C’ GFP library on the background of CCT mutant

N/A0N/AYes
